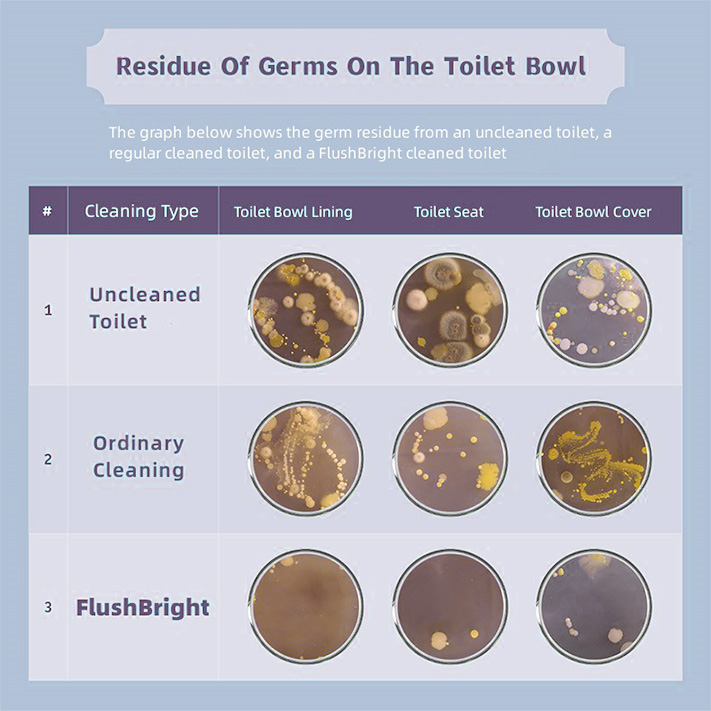

We've found a way to keep your toilet clean without having to "clean it"!
Even manual brushing of the toilet leads to the rearrangement of bacteria, dispersing up to 100,000 bacteria in the bathroom for several hours. This means that towels, basins, toothbrushes, and other items in the bathroom become breeding grounds for bacteria, forming a "cloud of viral particles."
As a result, you have to manually scrub the toilet yourself enduring the disgusting filth and odor and also spending a lot of time without cleaning it thoroughly.
The toilet that frees up your hands for complete cleaning is no longer a dream
FlushBright cleaning tablets utilize a foaming disintegrant cleaning principle. Simply place the FlushBright cleaning tablet into the toilet, and upon contact with water, it generates abundant bubbles with the ingredients in the product. The blind spots and deep-seated bacteria on the toilet walls are all engulfed by the foam, leaving no corner untouched. You don't need to "manually" clean the toilet, and you'll witness the dirt being washed away, making your toilet appear almost brand new.
But this isn't the most revolutionary change yet.
Traditional cleaning agents typically lose their effectiveness after just 20 minutes. In contrast, FlushBright cleaning tabs contain special probiotics that feed on various bacteria present in the toilet, such as staphylococcus, norovirus, E. coli, shigella, streptococcus, among others, some of which can survive on the toilet seat for up to 17 days. The special probiotics produce enzymes that break down the dirt and consume the residues as their food. As a result, the population of beneficial probiotics grows, even multiplying rapidly, while the living space for harmful bacteria diminishes. With probiotics consuming more dirt and propagating faster, the toilet remains clean for a longer time.
Experimental tests have shown that FlushBright is the best choice!
Test results indicate that traditional cleaning agents lose their effectiveness after about 20 minutes, while FlushBright cleaning tablets provide long-lasting cleaning for approximately a week. However, ordinary toilet cleaners can only clean visible areas, leaving behind 20-30% of harmful bacteria even after cleaning. In contrast, FlushBright cleaning tablets with "special probiotics" achieve "self-cleaning" while maintaining the bacterial content at only 10%! Furthermore, the probiotics also help to clear and prevent clogged drains, as they can adhere to the drain surface for an extended period and prevent debris buildup with their protective layer. This way, the toilet achieves long-lasting "self-cleaning."
What else can FlushBright do ?

- Forms An Enamel-protective Film
Ensure long-lasting shine and safeguarding against wear and tear. Traditional toilet cleaning agents can be harsh on enamel, leading to dull and worn-out surfaces over time. With FlushBright, you can bid farewell to such worries. Our cutting-edge technology allows the cleaning tablet to create a protective shield on the enamel, preventing stains, scratches, and discoloration caused by regular use.
- Environmental Protection
By using biodegradable and environmentally friendly tabs, you reduce the need for harmful chemicals found in traditional cleaning agents, making them a sustainable choice for toilet cleaning.
- Fragrance
Infused with pleasant scents, these tabs mask odors and create a fresh atmosphere in the restroom, allowing you to personalize your cleaning experience with various fragrance options.
Now 98% of FlushBright customers recommend this device to their friends

"Wow, these toilet cleaning tabs are like magic! My toilet looks and smells brand new after using them. It's like I just got a brand new toilet without the hassle and expense. Love it!"

"I never thought a small cleaning tab could make such a huge difference! My toilet was stained and grimy, but after using these cleaning tabs, it's sparkling clean. I can't stop showing it off to my friends!"

"Honestly, I was skeptical at first, but these cleaning tabs exceeded my expectations. They tackle tough stains and leave my toilet looking spotless. It's like a professional cleaning job in a little tablet!"

"My husband is notorious for leaving a mess in the bathroom, but these cleaning tabs have saved my sanity! They work wonders on stubborn stains and keep the toilet smelling fresh. It's a game-changer!"

"I never thought I'd be excited about cleaning my toilet, but these cleaning tabs are a game-changer. They make the process quick and easy, and my toilet has never looked cleaner. I'm actually looking forward to the next cleaning day!"
How Much Does It Cost?
A new toilet cleaning tablet is revolutionizing the way people think about toilet cleaning. Whether it's tackling tough stains or keeping your toilet fresh and germ-free, thousands of households have already adopted this remarkable technology and no longer need to spend hours scrubbing or using harsh chemicals. Say goodbye to manual cleaning and welcome the ease and efficiency of our toilet cleaning tablet!
So now FlushBright is running a sale for a limited time to make it even more affordable, and you can get up to 70% off.
It's the lowest price ever, so there's a real chance they'll run out of stock. At this price, it's a steal. Even FlushBright is so confident in its products that they offer a 30-day money-back service.
This is the only official site. DO NOT BUY ANYWHERE ELSE. Get the REAL THING. Buy the well-engineered, PREMIUM QUALITY FlushBright™ Toilet Cleaning Tablets and get all the advances and new technology built into it.
